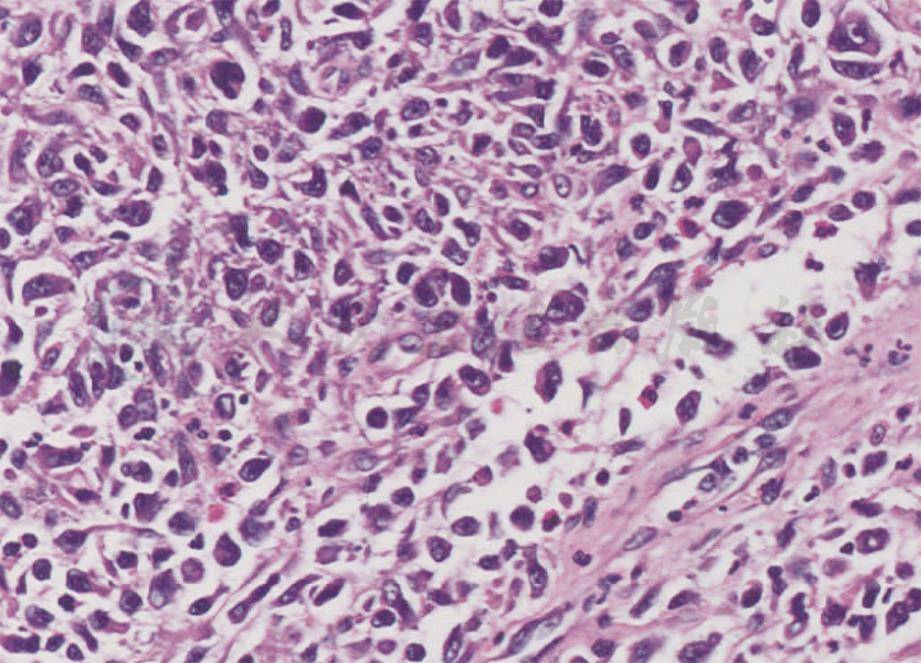

英文名称 :primary cutaneous anaplastic large cell lymphoma
原发性皮肤间变性大细胞淋巴瘤(primary cutaneous anaplastic large cell lymphoma,PC-ALCL)比较少见,中位诊断年龄为61岁,儿童也可发病,无明显性别倾向。多数患者表现为孤立或群集的结节(图1),经数周至数月生长,达到几厘米直径,常常形成溃疡。50%病例能部分消退,但很少完全消失。诊断时多发病灶较少见,复发时13%出现皮肤外转移。

图1原发性皮肤间变性大细胞淋巴瘤临床表现
右上肢孤立红色肿物,上覆结痂
特征为真皮致密细胞浸润,表皮受累少见,浸润的细胞由成片粘连的大CD30+肿瘤细胞组成(图2),细胞呈圆形或多形性,胞质丰富,嗜酸性,马蹄形胞核,核仁明显。肿瘤周围可见反应性淋巴细胞、组织细胞、嗜酸性粒细胞和中性粒细胞,溃疡性损害可见表皮增生。
组织化学染色可见75%肿瘤细胞表达CD30。多数病例表达CD4,伴有部分CD2、CD3和CD5抗原表达缺失,多数病例表达皮肤淋巴细胞相关抗原(cutaneous lymphocyte-associated antigen,CLA),不表达上皮细胞膜抗原(epithelial cell membrane antigen,EMA)和间变性淋巴瘤激酶(anaplastic lymphoma kinase,ALK)。多数病例可见TCR克隆性重排。
图2原发性皮肤间变性大细胞淋巴瘤组织病理表现
真皮内可见致密成片的大细胞浸润,部分细胞核异型性明显,还可见嗜酸性粒细胞(HE,200 ×)
本病进展缓慢,应注意避免过度治疗。
1.单发损害
可以进行手术切除或放疗,多数病例可以获得完全缓解,部分病例会复发,需要进一步治疗。
2.复发病例
根据病情来选择治疗手段。多发局限的复发病例可以进行再次手术,或放疗。由于部分皮损有自发缓解倾向,也可以在不影响患者生活的情况下定期随访观察。
3.多次复发、皮损泛发的病例
可以选择系统治疗。首选单一口服氨甲蝶呤,初始剂量15mg/周,最大剂量一般不超过25mg/周,皮损得到有效控制后可以减量,维持治疗不超过3年,病情再次复发时可以再次使用氨甲蝶呤。另外,也可以使用维A酸类药物(如贝沙罗汀)或干扰素。
4.对于以上治疗无效的患者
可以采用生物制剂(如本妥昔单抗),序贯化疗,联合化疗或同种异体造血干细胞移植。



